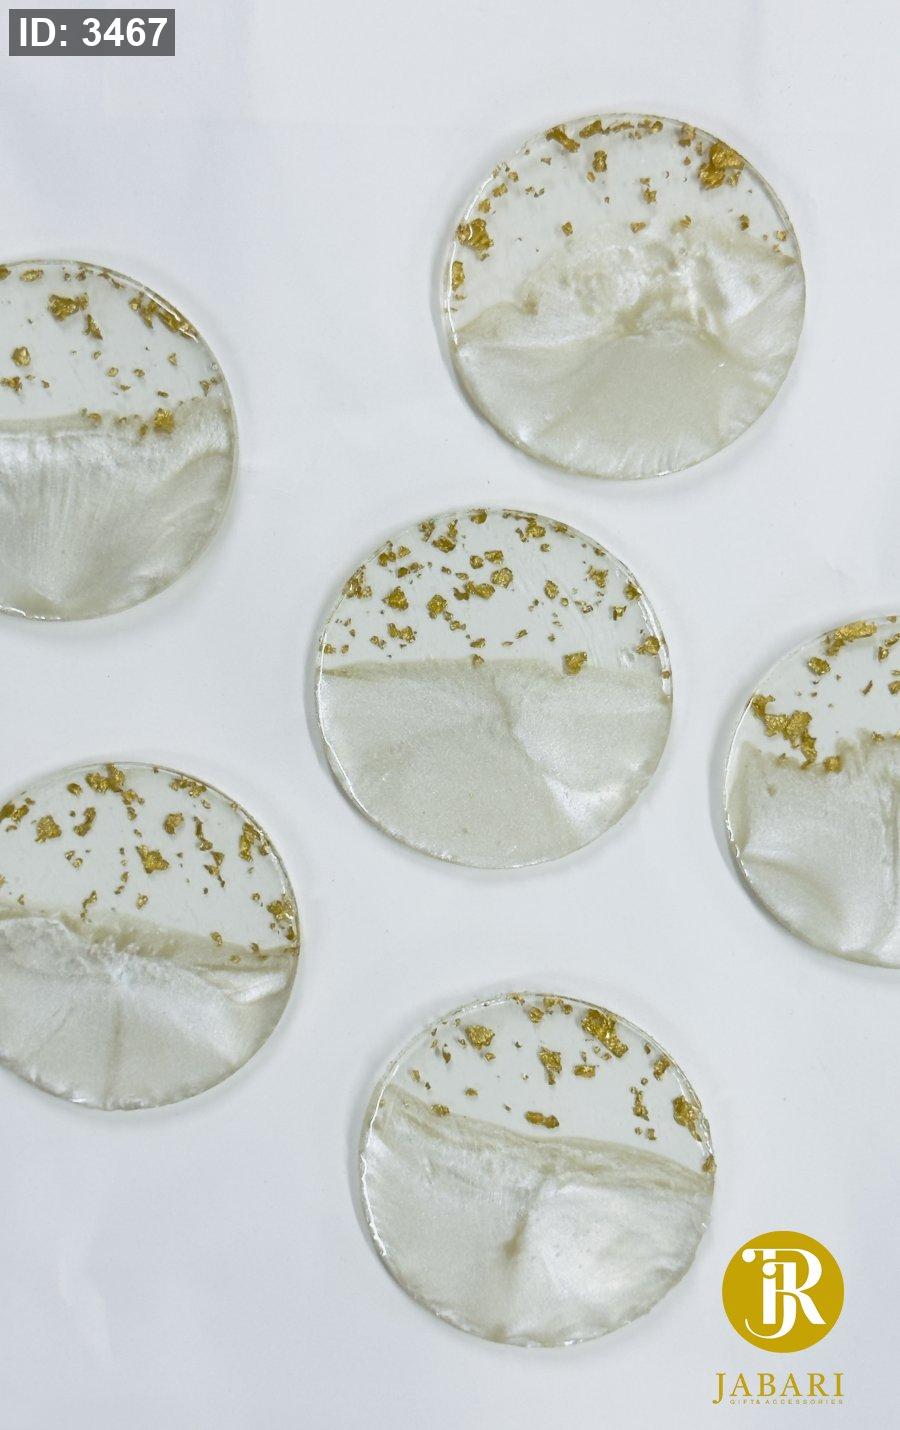

الرئيسية
زاوية هدايا رمضانية
هدايا و توزيعات
هدايا و توزيعات
قسم المباخر
قسم البخور
توزيعات سيراميك & حجر & رخام
سيراميك خارطة فلسطين مع مغناطيس
عطور & فواحات & أحجار معطرة
قسم المري
شنط إكسسوار
قطع و هدايا من الاكريلك
توزيعات كرتون
زجاجات العطور و الحنة
هدايا بلاستيك
شموع جاهزة
خشبيات
قطع ريزن جاهزة
مصاحف و مسابح
مداليات هدايا
أكياس منوعه
معلقات أبواب و اطارات ذهبية
هدايا خيزران & قش
هدايا معدن
يد و رقبة للاكسسوار
هدايا تخرج
دباديب
هديا زجاج
شوكلاتة للتوزيعات
ستاندات
مقصات زينة
مغناطيس
هدايا الحج و العمرة
قسم التغليف و لوازمه
قسم التغليف و لوازمه
اكياس كرتون & اكياس شفافة
علب PVC
صناديق شوكلاته ( تقسيم داخلي )
علب كرتون غطاء ( شفاف كامل & نافذة شفافة )
علب كرتون غطاء ( كرتون منفصل )
علب كرتون ( نافذة شفاف ) مع تقسيم داخلي
علب كرتون غطاء ( كرتون سحاب )
صناديق كرتون ( نافذة شفاف )
علب & صناديق ( كرتون بالكامل ) مع يد و شبر
علب كرتون غطاء ( بلور سحاب )
علب كرتون ( نافذة شفاف )
اكياس سلفان لاصق
أكياس سلفان مع قلوب
قسم ورق التغليف
ورق جريدة
رولات تغليف
اختام شمعية
غطاء طاولات
ورد صناعي و ورق مقصقص
اكياس هدايا تركي
قطع صغيرة للزينة
ببيونات
صناديق 📌 تحف 📌 صواني 📌 للدبل و الشوكلاته
قسم الشمع و الصابون الخام ولوازمهم .
أواني و كاسات
إيبوكسي ريزين
صبغات و ملونات
قسم الشبر & الخيش & الكلف
ورد طبيعي مجفف
مقصات
منوعات
لوازم صناعة الإكسسوارات و الخرز
خياطة و لوازمها 📌 إكسسوارات
أدوات و لوازم التطريز
قسم الصوف التركي
عرض كل المنتجات
وصل حديثاً
عروض وخصومات
تحدث الينا - واتساب
تابعنا على فيس بوك
الرئيسية
زاوية هدايا رمضانية
هدايا و توزيعات
هدايا و توزيعات
قسم المباخر
قسم البخور
توزيعات سيراميك & حجر & رخام
سيراميك خارطة فلسطين مع مغناطيس
عطور & فواحات & أحجار معطرة
قسم المري
شنط إكسسوار
قطع و هدايا من الاكريلك
توزيعات كرتون
زجاجات العطور و الحنة
هدايا بلاستيك
شموع جاهزة
خشبيات
قطع ريزن جاهزة
مصاحف و مسابح
مداليات هدايا
أكياس منوعه
معلقات أبواب و اطارات ذهبية
هدايا خيزران & قش
هدايا معدن
يد و رقبة للاكسسوار
هدايا تخرج
دباديب
هديا زجاج
شوكلاتة للتوزيعات
ستاندات
مقصات زينة
مغناطيس
هدايا الحج و العمرة
قسم التغليف و لوازمه
قسم التغليف و لوازمه
اكياس كرتون & اكياس شفافة
علب PVC
صناديق شوكلاته ( تقسيم داخلي )
علب كرتون غطاء ( شفاف كامل & نافذة شفافة )
علب كرتون غطاء ( كرتون منفصل )
علب كرتون ( نافذة شفاف ) مع تقسيم داخلي
علب كرتون غطاء ( كرتون سحاب )
صناديق كرتون ( نافذة شفاف )
علب & صناديق ( كرتون بالكامل ) مع يد و شبر
علب كرتون غطاء ( بلور سحاب )
علب كرتون ( نافذة شفاف )
اكياس سلفان لاصق
أكياس سلفان مع قلوب
قسم ورق التغليف
ورق جريدة
رولات تغليف
اختام شمعية
غطاء طاولات
ورد صناعي و ورق مقصقص
اكياس هدايا تركي
قطع صغيرة للزينة
ببيونات
صناديق 📌 تحف 📌 صواني 📌 للدبل و الشوكلاته
قسم الشمع و الصابون الخام ولوازمهم .
أواني و كاسات
إيبوكسي ريزين
صبغات و ملونات
قسم الشبر & الخيش & الكلف
ورد طبيعي مجفف
مقصات
منوعات
لوازم صناعة الإكسسوارات و الخرز
خياطة و لوازمها 📌 إكسسوارات
أدوات و لوازم التطريز
قسم الصوف التركي
عرض كل المنتجات
وصل حديثاً
عروض وخصومات
تحدث الينا - واتساب
تابعنا على فيس بوك
تثبيت تطبيق "الجعبري للنثريات و الاكسسوارات"